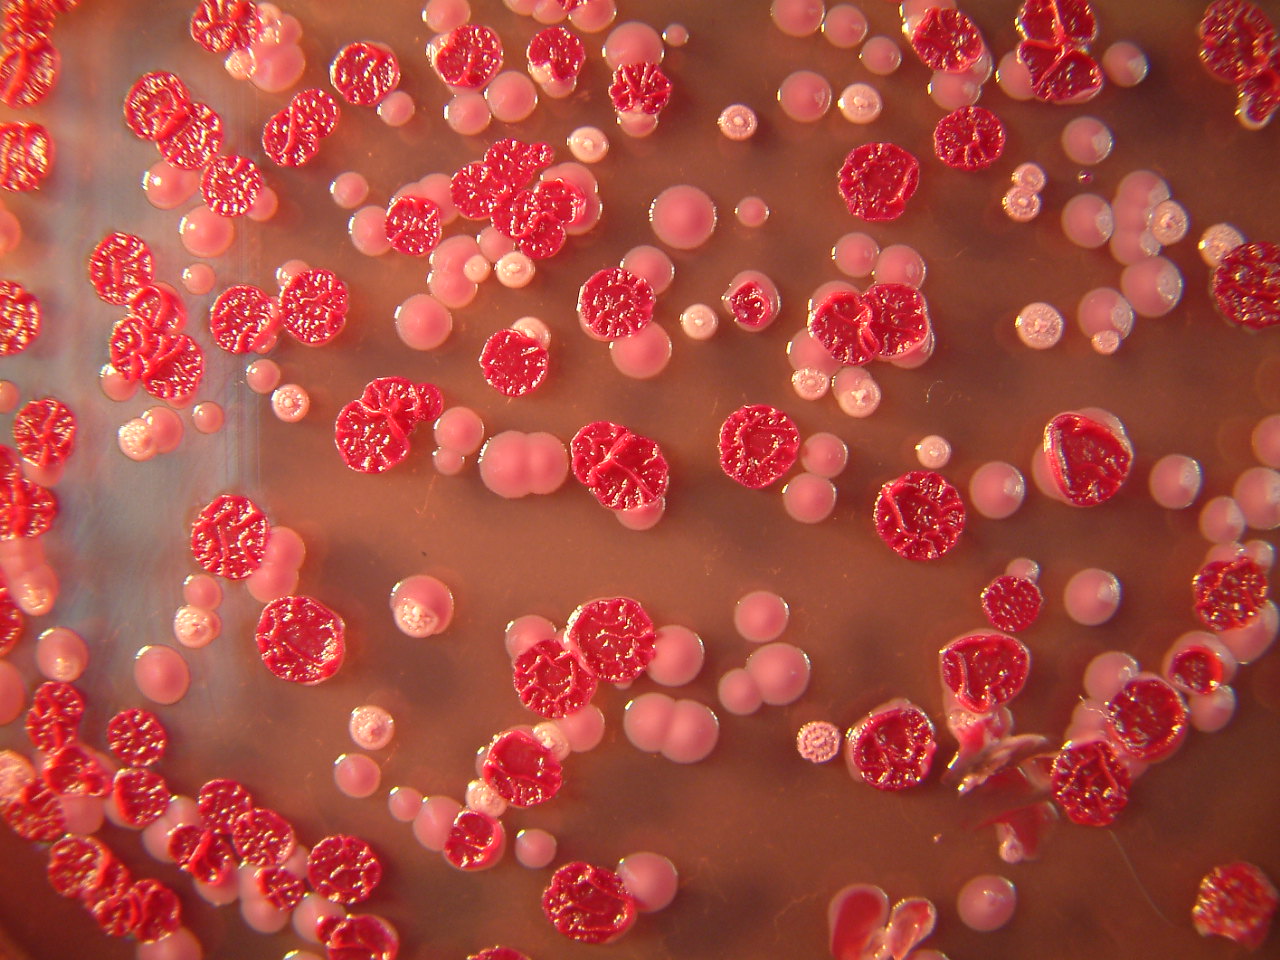
Tin tức trong ngày - Mỹ: Phòng thí nghiệm để lọt vi khuẩn chết người ra ngoài

Nhật Bản: Vi khuẩn "ăn thịt người" tấn công hơn 500 người
Hơn 500 người ở Nhật Bản đã bị nhiễm STSS hay còn được gọi là “vi khuẩn ăn thịt người” trong năm nay.
Khuẩn dạng cầu chuổi Nhóm A có thể gây ra các bệnh nhiễm trùng nguy hiểm.
Tờ Asahi Shimbun dẫn số liệu từ Viện nghiên cứu bệnh truyền nhiễm quốc gia Nhật Bản, cho biết khoảng 525 người ở nước này đã bị nhiễm hội chứng sốc nhiễm khuẩn cầu chuỗi (STSS) trong năm 2017. Bệnh này gây hoại tử chân và cơ quan nội tạng, khiến bệnh nhân có thể tử vong trong vài giờ.
Trong số các trường hợp nhiễm STSS, 66 người ở Tokyo, 40 người ở Kanagawa, 32 người ở Aichi, 31 người ở Fukuoka và 28 người ở Hyogo. Phần lớn các bệnh nhân đều hơn 30 tuổi.
Bệnh STSS thu hút sự chú ý gần đây sau khi cựu người mẫu và vận động viên điền kinh Mỹ Lauren Wasser chia sẻ câu chuyện cô bị nhiễm “vi khuẩn ăn thịt người” do sử dụng băng vệ sinh quá lâu. Hậu quả là cô đã bị cắt bỏ chân phải.
Bệnh thường lây truyền qua tiếp xúc với vết thương viêm nhiễm và bắt đầu với triệu chứng sốt, sưng và đau ở chân và tay. Khi vi khuẩn lây lan khắp có thể qua đường máu, chúng bát đầu "ăn" các cơ quan nội tạng và thịt, khiến bệnh nhân rơi vào tình trạng hôn mê, rối loạn và thậm chí tử vong.
Theo Trung tâm kiểm soát dịch bệnh Mỹ, tỉ lệ tử vong của bệnh nhân nhiễm STSS rất cao, lên tới hơn 50%. Mặc dù vậy, bệnh có thể được điều trị sớm bằng thuốc kháng sinh hoặc cắt bỏ các phần chi bị hoại tử.
Kẹt xe có thể khiến con người suy thoái hành vi, nhân cách và đưa ra các quyết định sai lầm.